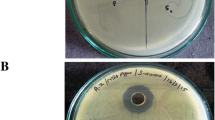

Abstract
The purpose of this study was to investigate the effects of manuka honey on the structural integrity of Pseudomonas aeruginosa ATCC 27853. The minimum inhibitory concentration (MIC) and the minimum bactericidal concentration (MBC) of manuka honey for P. aeruginosa were determined by a microtitre plate method, and the survival of bacteria exposed to a bactericidal concentration of manuka honey was monitored. The effect of manuka honey on the structure of the bacteria was investigated using scanning and transmission electron microscopy (SEM and TEM, respectively). The MIC and MBC values of manuka honey against P. aeruginosa were 9.5% (w/v) and 12% (w/v) respectively; a time–kill curve demonstrated a bactericidal rather than a bacteriostatic effect, with a 5 log reduction estimated within 257 min. Using SEM, loss of structural integrity and marked changes in cell shape and surface were observed in honey-treated cultures. With TEM, these changes were confirmed, and evidence of extensive cell disruption and lysis was found. Manuka honey does not induce the same structural changes in P. aeruginosa as those observed in staphylococci. Our results indicate that manuka honey has the potential to be an effective inhibitor of P. aeruginosa.
Similar content being viewed by others
Avoid common mistakes on your manuscript.
Introduction
Pseudomonas aeruginosa is an opportunist pathogen that is ubiquitously distributed throughout the environment, particularly in moist habitats. It has been implicated in a wide range of infections, such as endocarditis, folliculitis, keratitis, meningitis, pneumonia, urinary tract infections and wound infections. In wounds, P. aeruginosa has emerged as a multidrug-resistant organism that gives rise to persistent infections in burns patients [1, 2] and chronic venous leg ulcers [3]. Novel antimicrobial interventions are needed.
Honey has been used for thousands of years as a topical treatment for wounds. Although ancient remedies may have been crude preparations, modern wound care products are standardised to satisfy regulatory constraints. The use of honey in modern clinical practice is based on its broad antimicrobial properties and its ability to stimulate rapid wound healing. Antimicrobial activity extends to more than 80 species [4, 5]. The inhibition of pathogens capable of causing wound infection has been demonstrated [6–10], with both antibiotic-resistant and antibiotic-sensitive strains exhibiting susceptibility to honey [6, 7, 11].
The complex chemistry of honey has complicated attempts to understand its mode of action, but the contributions of individual antibacterial components have been identified [12]. Recently, macroarray transcriptome analysis with Escherichia coli has shown that a blend of Leptospermum honeys induces a unique response that involves multiple cellular targets [13]. Manuka honey prevents cell division in Staphylococcus aureus and leads to the accumulation of cells with septa [14]; its effect on the structure of Gram-negative bacteria has not been studied. This pilot study, therefore, aims to investigate the effects of manuka honey on the structural integrity of a bacterium commonly associated with wound infection, in order to gain insight into its action as an inhibitory agent.
Materials and methods
General
A culture of P. aeruginosa ATCC 27853 was tested with a sample of manuka honey (M109) that was a gift from Prof. Molan of the University of Waikato, New Zealand. The antibacterial potency of the sample was equivalent to 18% (w/v) phenol using a bioassay developed in New Zealand [15].
Minimum inhibitory concentrations and minimum bactericidal concentrations
The minimum inhibitory concentration (MIC) was determined in 96-well, flat-bottomed microtitre plates (Nunc, Roskilde, Denmark) using double-strength nutrient broth (Oxoid, Basingstoke, UK) and honey concentrations varying by 1% (w/v) intervals in a total volume of 200 μL. Overnight broth cultures of the test organism (1 μL) was used as an inoculum without dilution, and total viable cell counts were performed to check retrospectively that each well had received approximately 106 cells. Plates were incubated at 37°C for 24 h and turbidity measured at 400 nm in a plate reader (Anthos Labtec Instruments). Positive (broth and inoculum) and negative (broth and honey) controls were included. Wells with the lowest concentration without growth were recorded as the MIC. The minimum bactericidal concentration (MBC) was determined by plating 20 μL from wells without growth onto nutrient agar (Oxoid, Basingstoke, UK) and incubating at 37°C for 24 h to find the lowest concentration without viable bacteria. Experiments were performed in duplicate on each of three occasions.
Time–kill curve
A time–kill study was performed by inoculating 40 μL of an overnight culture of P. aeruginosa ATCC 27853 into 20 mL nutrient broth with and without 20% (w/v) M109 and incubating at 37°C for 24 h in a shaking water bath (120 cycles min−1) (the honey concentration was approximately twice the MIC value). Samples were removed at known intervals and Miles and Misra surface drop counts were performed by serial decimal dilution in quarter-strength Ringer’s solution, plating onto nutrient agar and incubating at 37°C for 24 h.
Electron microscopy
Electron microscopy was performed using the test organism in either the exponential or stationary phase of growth following cultivation in Iso-Sensitest broth (Oxoid, Basingstoke, UK) at 37°C in a shaking water bath for either 3 h or overnight, respectively. Cells were harvested by centrifugation at 3,000g for 30 min (MSE harrier 15/80 centrifuge, Sanyo) at room temperature and suspended in MOPS buffer (pH 7.2) with and without 20% (w/v) manuka honey for 8 h, or in MOPS buffer containing 20% (w/v) artificial honey solution to determine the effect of sugars in honey on the cell structure [6, 7]. Cells were examined using scanning (5200LV Jeol, Herts, UK) and transmission electron microscopy (SEM and TEM, respectively) (1210 Jeol, Herts, UK) by the method of Lemar et al. [16], except that harvested cell pellets for TEM were embedded in Araldite resin, not Spurr.
Analysis of images
Electron micrographs of untreated and treated cells were examined to identify structural changes such as altered shape, modified surface layers, the presence of electron-dense material and cellular debris. Typically, at least six photographs, each with approximately 160 cells, were observed, so that more than 1,000 cells were counted in total for each sample. The data were analysed for statistically significant differences by the Mann–Whitney test using Minitab (version 15).
Results
Inhibition studies
The MIC and MBC were found to be 9.5% (w/v) and 12% (w/v) manuka honey, respectively. The close proximity of these two values indicates a bactericidal mode of inhibition. This was confirmed by time–kill studies (Fig. 1), where cells exposed to manuka honey were found to lose viability with time, yet the numbers of untreated cells increased. The time estimated to achieve a 5 log reduction of test organism incubated with nutrient broth containing 20% (w/v) manuka honey was 257 min.
Structural studies
The effect of manuka honey on cell structure was investigated in both exponential and stationary phase cultures because stationary phase cells are often less susceptible to antimicrobial agents than exponential cells. However, the structural changes observed in both of these stages of growth were similar and, therefore, only electron micrographs of exponential cells are presented here.
Using SEM, the smooth surface layers of untreated cells (Fig. 2a) and cells exposed to 20% (w/v) artificial honey (Fig. 2b) contrasted with those of honey-treated P. aeruginosa cells, which exhibited marked cell surface changes as furrows and blebs (Fig. 2c). Honey-treated cells also appeared to be shortened and to have distorted shapes (Fig. 2c). In untreated samples, 2% of cells were found to have structural irregularities, whereas 80% and 60% cells of exponential and stationary cultures, respectively, exhibited irregular cell structure. These differences were statistically significant (Table 1). For exponential phase cells exposed to 20% (w/v) artificial honey, 7% of cells were found to exhibit structural irregularities. This suggests that the effect of manuka honey on P. aeruginosa is not due exclusively to the sugars contained in honey.
The effect of manuka honey on the structure of exponential phase bacteria as seen by scanning electron microscopy (SEM). a Exponential phase cells of P. aeruginosa incubated with MOPS buffer for 8 h at 37°C as viewed by SEM at 10,000× magnification. b Exponential phase cells P. aeruginosa incubated with MOPS buffer containing 20% (w/v) artificial honey for 8 h at 37°C as viewed by SEM at 10,000× magnification. c Exponential phase cells of P. aeruginosa incubated with MOPS buffer containing 20% (w/v) manuka honey for 8 h at 37°C as viewed by SEM at 10,000× magnification
Using TEM, untreated cells (Fig. 3a) and cells incubated in MOPS containing 20% (w/v) artificial honey (Fig. 3b) were entire cells with relatively densely stained contents. In the TEM images of honey-treated P. aeruginosa (Fig. 3c), cellular debris was clearly evident and whole cells with evacuated areas were observed.
The effect of manuka honey on the structure of exponential phase bacteria as seen by SEM. a Exponential phase cells of P. aeruginosa incubated with MOPS buffer for 8 h at 37°C as viewed by transmission electron microscopy (TEM) at 10,000× magnification. b Exponential phase cells of P. aeruginosa incubated with MOPS buffer containing 20% (w/v) artificial honey for 8 h at 37°C as viewed by TEM at 20,000× magnification. c Exponential phase cells of P. aeruginosa incubated with MOPS buffer containing 20% (w/v) manuka honey for 8 h at 37°C as viewed by TEM at 10,000× magnification
Discussion
Inhibition studies
The MIC obtained in this study concurred with previous studies [6, 9, 10]. The MBC and time–kill curve (Fig. 1) indicated a bactericidal rather than bacteriostatic effect of manuka honey on P. aeruginosa. The loss of viability of cells exposed to 20% (w/v) manuka honey in vitro provided a guide to its clinical efficacy, where in licensed wound dressings undiluted honey is usually used. Since part of the weight of the dressing is absorptive material, honey is not diluted in terms of its antibacterial activity, even though the quantity of honey in terms of the total weight of the dressing applied to the wound is decreased.
Structural studies
The loss of structural integrity in P. aeruginosa treated with manuka honey was unlike that observed in S. aureus, where increased numbers of cells with septa were evident [14]. The presence of cellular debris in TEM images indicated that P. aeruginosa had lysed and whole cells in SEM images were short, distorted and displayed cell surface abnormalities.
The results of this preliminary study demonstrate that manuka honey is an effective inhibitor of P. aeruginosa. Further investigation into its effect on cellular and molecular targets is warranted, and its clinical efficacy must be confirmed.
References
Branski LK, Al-Mousawi A, Rivero H, Jeschke MG, Sanford AP, Herndon DN (2009) Emerging infections in burns. Surg Infect 10(5):389–397
Keen EF 3rd, Robinson BJ, Hospenthal DR, Aldous WK, Wolf SE, Chung KK, Murray CK (2010) Prevalence of multidrug-resistant organisms recovered at a military burn center. Burns 36(6):819–825
Fazli M, Bjarnsholt T, Kirketerp-Møller K, Jørgensen B, Andersen AS, Krogfelt KA, Givskov M, Tolker-Nielsen T (2009) Nonrandom distribution of Pseudomonas aeruginosa and Staphylococcus aureus in chronic wounds. J Clin Microbiol 47(12):4084–4089
Blair SE, Carter DA (2005) The potential for honey in the management of wound and infection. J Australian Infection Control 10:24–31
Molan PC (1992) The antibacterial activity of honey. 1. The nature of the antibacterial activity. Bee World 73:5–28
Cooper RA, Halas E, Molan PC (2002) The efficacy of honey in inhibiting strains of Pseudomonas aeruginosa from infected burns. J Burn Care Rehabil 23:366–370
Cooper RA, Molan PC, Harding KG (2002) The sensitivity to honey of Gram-positive cocci of clinical significance isolated from wounds. J Appl Microbiol 93:857–863
French VM, Cooper RA, Molan PC (2005) The antibacterial activity of honey against coagulase-negative staphylococci. J Antimicrob Chemother 56:228–231
Wahdan HAL (1998) Causes of the antimicrobial activity of honey. Infection 26:26–31
Willix DJ, Molan PC, Harfoot CG (1992) A comparison of the sensitivity of wound-infecting species of bacteria to the antibacterial activity of manuka honey and other honey. J Appl Bacteriol 73:388–394
Karayil S, Deshpande SD, Koppikar GV (1998) Effect of honey on multidrug resistant organisms and its synergistic action with three common antibiotics. J Postgrad Med 44:93–96
Kwakman PH, te Velde AA, de Boer L, Speijer D, Vandenbroucke-Grauls CM, Zaat SA (2010) How honeys kills bacteria. FASEB J 24(7):2576–2582
Blair SE, Cokcetin NN, Harry EJ, Carter DA (2009) The unusual antibacterial activity of medical-grade Leptospermum honey: antibacterial spectrum, resistance and transcriptome analysis. Eur J Clin Microbiol Infect Dis 28(10):1199–1208
Henriques AF, Jenkins RE, Burton NF, Cooper RA (2009) The intracellular effects of manuka honey on Staphylococcus aureus. Eur J Clin Microbiol Infect Dis 29:45–50. doi:10.1007/s10096-009-0817-2
Allen KL, Molan PC, Reid GM (1991) A survey of the antibacterial activity of some New Zealand honeys. J Pharm Pharmacol 43(12):817–882
Lemar KM, Turner MP, Lloyd D (2002) Garlic (Allium sativum) as an anti-Candida agent: a comparison of the efficacy of fresh garlic and freeze-dried extracts. J Appl Microbiol 93:398–405
Acknowledgements
We wish to thank Drs. Hann and Turner of the Electron Microscope Unit at Cardiff University, Wales, UK.
Author information
Authors and Affiliations
Corresponding author
Rights and permissions
About this article
Cite this article
Henriques, A.F., Jenkins, R.E., Burton, N.F. et al. The effect of manuka honey on the structure of Pseudomonas aeruginosa . Eur J Clin Microbiol Infect Dis 30, 167–171 (2011). https://doi.org/10.1007/s10096-010-1065-1
Received:
Accepted:
Published:
Issue Date:
DOI: https://doi.org/10.1007/s10096-010-1065-1